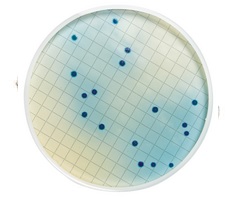
MB000000R.jpg

ACIDO ROSOLICO INDICADOR EMB C/ 25g MILLIPORE
Modelo: MB000000R
R$ 3.001,56
ou até 3x de R$ 1.000,52 sem juros
Economize 5% no PIX: R$ 2.851,48
ou 3,5% no boleto: R$ 2.896,51
Calcular Frete
Descrição
Selective agent to be added to mFC broth medium, Beer, Bottled Water, Cider, Microbial monitoring, Soft Drink, Sport Drink, Wine
